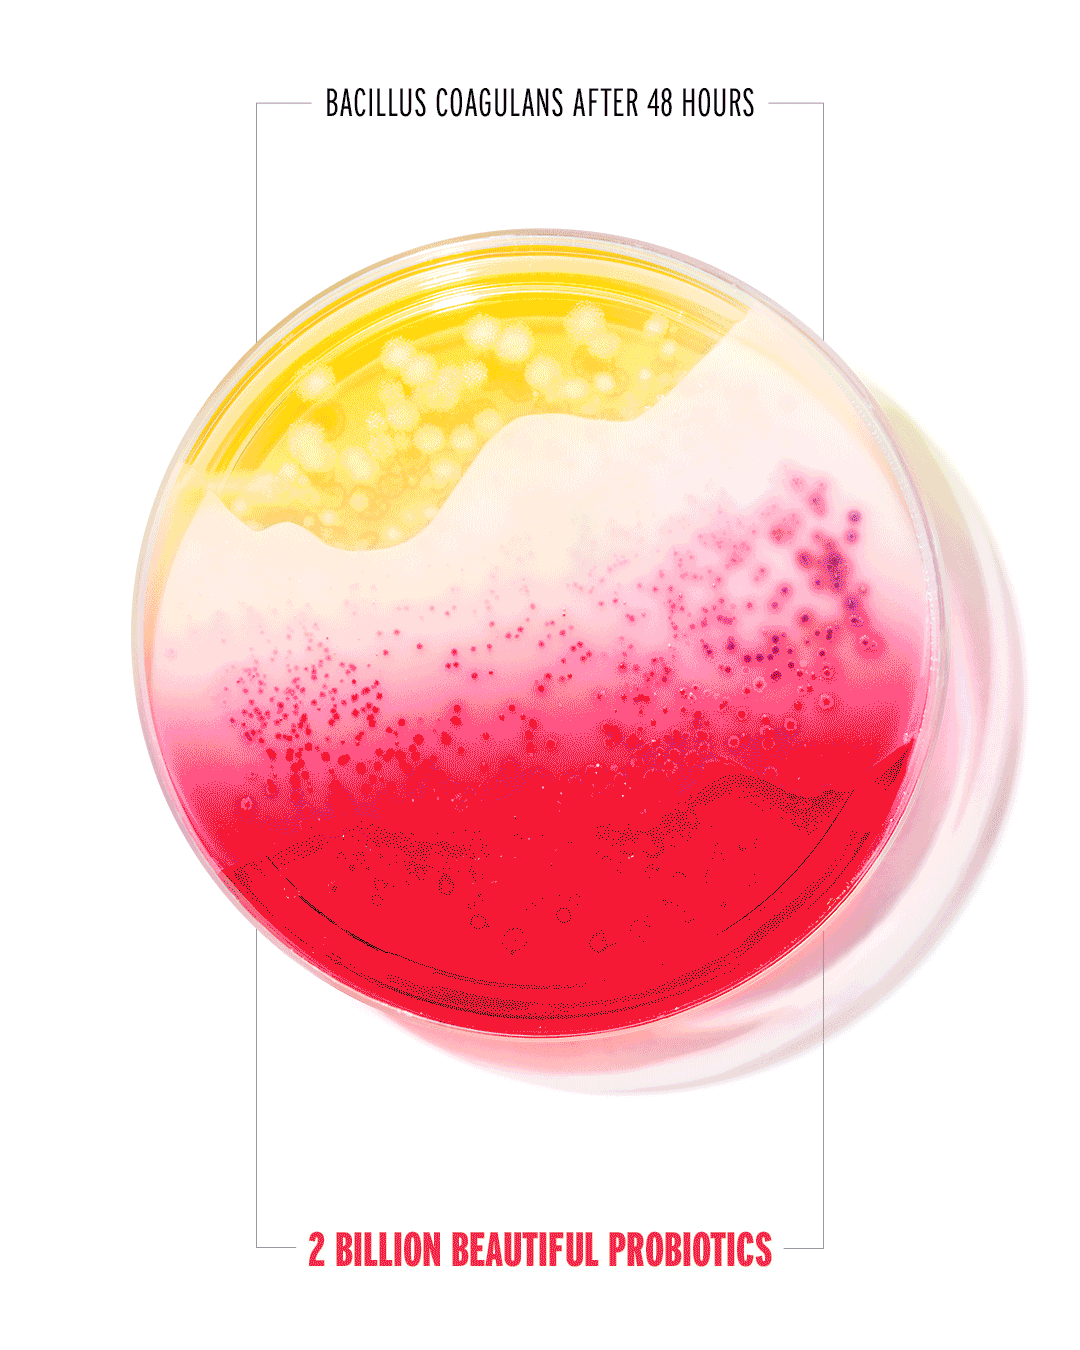

Learn
Now that's embarrassing, someone has forgotten to load up all the blog articles so now we look like dicks. We're fixing this pronto.
No Ugly Turns Inner Gut Beauty into Art in new campaign by Droga5 Aotearoa
Isn’t science beautiful?
Cultivated at 37°C to mirror the warmth of the human body, the live probiotics in every can of No Ugly Gut flourish into stunning patterns on nutrient-rich agar plates.
Learn more
MENTAL HEALTH CHAMPION, COREY CHOAT
Corey Choat is not a 'runner', but after losing his sister Sal to suicide, he's running to raise awareness & money for Gumboot Friday. He's clocked up almost 2,000km and raised over $40,000. We think that's pretty gorgeous.
Learn more
Top Tips for Getting Better Shut-Eye
If you're struggling with your sleep, it can be frustrating at best, debilitating at worst - but there are a lot of ways to help your body get ready for slumber.
Learn more
When you can't sleep
Sleep expert Olivia Arezzolo separates fact from fiction, so you can get the sleep you want, love and so desperately need.
Learn more
OVERNIGHT SENSATION: DR ANN SHIVAS OF SLEEP LOOP
Meet the doctor behind the wellness industry’s newest sleep offering — a tonic that is said to help you drift off to the land of nod
Learn more
COLLAGEN – THE BEST BEAUTY BOOSTER
See what Spa & Wellness Magazine had to say about No Ugly Skin
Learn more
Hello No Ugly Libido
No Ugly's Wellness Podcast hosted by Somatic Sexologist and co-host of The Trainee Sexologist Podcast, Morgan Penn, who chats with Sarah Walter, No Ugly’s Food Scientist and Sara Eichmann, Head of Operations, about No Ugly’s latest wellness tonic No Ugly Libido, in a hilarious, yet informative episode.
Learn more
No Ugly Founders discuss mental health with Toni Street
Aaron and Jo Taylor, founders of No Ugly, were lucky enough to chat to Toni Street on her podcast "We Need To Talk" about Mental Health, the challenges they have experienced as a family and why they developed No Ugly Calm.
Learn more
